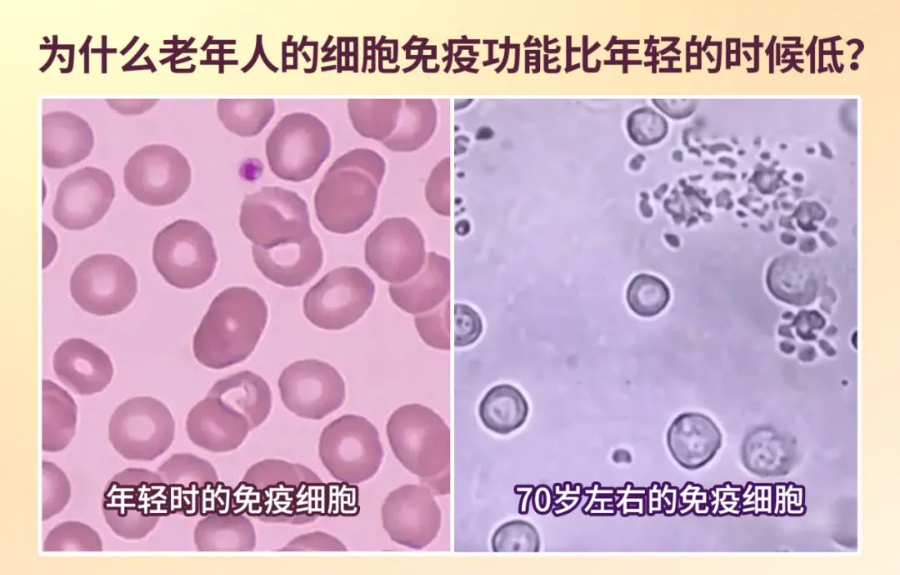

什么是免疫力?
免疫力简单说就是指免疫细胞的数量和战斗能力,是机体抵抗外来侵袭、维护体内环境稳定,清除衰老变异物质的基本的能力,是人体健康的军事力量。
免疫力是人体天然的防御系统。当外界的细菌、病毒等入侵时,人体的免疫细胞如“战士”迅速出击,免疫细胞大军会联合作战,抵御、消灭外来病毒的入侵,将人类的健康牢牢守护。

人体免疫力强时,身体对抗外来病毒、细菌入侵的能力才可以提高,这样有害物质想要影响身体健康的可能性就会降低。但是免疫力低下,就容易出现各种健康问题。比如容易感冒、食欲不振、脾气大、失眠、经常便秘等。

哪些因素会影响免疫力?
首先是年龄因素,30岁人体免疫力达到巅峰,以后开始缓慢、持续的降低,随着器官功能的衰退,免疫器官也开始萎缩,免疫力逐渐下降。人体就像一部机器,用久了零件会磨损,就常因过度使用而老化,伴随发生的一系列退行性病变影响身体的健康。

T淋巴细胞是免疫功能的主力军。T淋巴细胞在骨髓中产生,在胸腺的激活作用下才能具有细胞免疫的功能。人的胸腺从中年开始平均每年以3%的速度不断萎缩。大约在70岁左右,胸腺可能全部萎缩。这时,人体将不会再产生新的、成熟的T淋巴细胞,这也就解释了为什么老年人的细胞免疫功能比年轻的时候低。
其次是精神心理因素,各种压力,导致人们过度紧张,焦虑,悲观,不良情绪会对免疫系统造成伤害,所以任何时候都应保持一种平和乐观的心态;再者是不良生活习惯,比如熬夜,睡眠不足,营养不均衡,吸烟酗酒,长期缺乏健身运动。
如何提升免疫力?
各种原因导致免疫系统不能正常发挥保护作用,在此情况下,易招致细菌、病毒、真菌等感染,因此免疫力低下最直接的表现就是容易生病,患病当然得去看医生,治疗过程中,在进行“三分治”的同时,应认真进行“七分养”,药物治疗固然需要,而注意调养尤其不能忽略。俗话说的 “三分治疗七分调养”确是经验之谈。
随着年龄的增加,免疫力递减是正常生理现象,虽然这种趋势难以改变,但如果采取一定的科学保健措施,便可有效地延缓免疫力退化。养成健康的生活方式,保持心理和谐,合理营养与均衡膳食,适量规律运动,保证充足的睡眠。

免疫力好帮手——“灵芝孢子粉”
提高自身免疫力
《神农本草经》将灵芝列为上品,被视为滋补强壮、扶正固本的珍品。灵芝孢子,即成熟的灵芝子实体弹射的种子,我们习惯称呼灵芝孢子粉。

灵芝孢子粉中主要的活性物质包括三萜类化合物和多糖。三萜类化合物和多糖在灵芝孢子粉中不仅含量较高,而且能参与机体免疫应答效应。主要是通过直接作用于免疫细胞、发挥免疫活性功能实现的。
灵芝三萜类包括100多种化合物,能够刺激机体免疫修复,发挥免疫调节作用,提高自身免疫力,从而达到抗病毒、抗氧化等作用。
灵芝多糖是灵芝“扶正固本”的有效成分,研究表明,灵芝多糖具有广泛的活性,具有提高机体免疫力、增强机体耐缺氧能力、消除自由基、抗衰老等作用。

补气益肺
空气中布满了各种灰尘和细菌,细菌侵入呼吸系统,免疫系统是人体抵抗病毒和细菌感染的能力,所以免疫力比较弱的人非常容易受到一些呼吸疾病的感染。
灵芝,又名神芝、瑞草,具有良好的安神补气、平喘止咳功效,可用于缓解心悸气短、体弱、哮喘等症状。《本草纲目》记载灵芝“益肺气”,具有补肺健脾、定喘止咳作用。灵芝孢子粉对呼吸系统有镇咳、祛痰作用,促进支气管表皮细胞再生。

保肝护肝、改善睡眠
《医碥》云:经常情绪低落、烦躁不安、忧愁伤感,则肝气郁结,上扰心神而出现不寐。
灵芝孢子粉是养肝护肝之上品,具有保肝,双向调节免疫的作用。灵芝孢子粉可以加强肝脏藏血、代谢、疏泄等功能,在减轻酒精、化学药物等对肝脏损伤上,表现突出。
灵芝对于中枢神经系统有较强的调节作用,具有镇静安神的功效,对于神经衰弱和失眠是必备佳品,全国中草药汇编中,灵芝就被誉为有效安眠宁神。